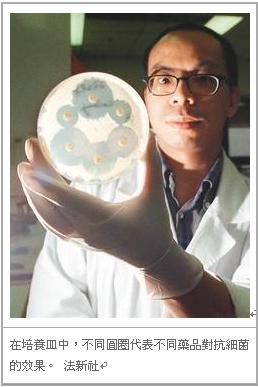

精選
超級細菌解析/超級細菌 天不怕地不怕?
2010/11/01 10:45
瀏覽517
迴響0
推薦0
引用0
2010/11/01
【聯合報╱記者劉惠敏】
歐洲的科學家近期才發出警告:疑似源於印度等南亞國家的「超級細菌」NDM-1可能擴散威脅全球人類健康。不到一個月後,臺灣也遭該超級細菌侵襲。
衛生署立即公告「NDM-1腸道菌感染症」列入第四類法定傳染病,其後證實在印度遭受槍傷意外的某媒體外景攝影師,在當地就醫時感染了帶有抗藥性基因的肺炎克雷白氏菌,所幸該患者並未發病,屬於腸道無症狀「帶菌者」,也讓政府與國人鬆了一口氣。
根據國外報導,「超級細菌」讓曾是現代醫學對抗傳染病、微生物感染的最重要武器—抗生素一路挫敗,難道一旦染上超級細菌真的會無藥可治?
超菌不是單一菌種
在擔心憂慮前,先介紹公眾認識這些超級細菌是何方神聖。首先,超級細菌不是單一菌種,也非首次出現在人類醫學史上。
最近聲名大噪的超級細菌「NDM-1」,是New-Delhi metallo beta-lactamas(新德里金屬β內醯胺1型)的簡稱,是一種可產生酵素、破壞抗生素的細菌基因。
攜帶多種抗藥基因
所謂超級細菌(super bug),其實是攜帶多種抗藥性基因的細菌,即「多重抗藥性」細菌的俗稱。
中央研究院生物醫學研究所副所長廖有地說,面對抗生素這個「敵人」,細菌會利用不同的遺傳工具、不斷地改變遺傳策略,有效增加生存機會。
廖有地說,抗生素的作用機制各有不同,細菌在繁殖、生長過程中,會不斷分裂增生。有些抗生素會抑制細菌細胞壁合成,如盤尼西林;或抑制細菌蛋白質的合成,如老虎黴素;或是干擾細菌DNA(去氧核糖核酸)的複製或轉錄,抑制細菌重要新陳代謝物的合成等各種機制。
另外有些抗生素的作用則是破壞細菌細胞外膜,讓抗菌藥物能侵入細菌細胞,使細菌內含物凝結成一團進而導致細菌死亡。
由於細菌對許多抗生素出現抗藥性,科學界正積極尋找新的抗生素。廖有地說,中研院團隊也正朝研究新作用機制的抗生素方向發展;不同於傳統抗生素,新型的抗生素希望在細菌細胞繁殖分裂前,即達到殺菌作用,以期減少抗藥性的產生。
抗藥性機制有4種
細菌抗藥性的機制可分為4種形式。
第一種是產生破壞抗生素作用的酵素。就像 NDM-1,屬於 β-內醯胺酶(β-lactamase)酵素。張上淳解釋,細菌分裂繁殖、合成細胞壁可能需要多種酵素作用,有的抗生素就是抑制這些酵素,使其不能合成細胞璧;但抗藥性的基因分泌其他酵素,就像「反飛彈裝置」,破壞抗生素。
第二種是細菌鞏固自身「碉堡」。抗生素會攻擊細菌核糖體,所以細菌透過改變或是隱藏自體結構機制,產生抗藥性,例如最常見的超級細菌「抗藥性金黃色葡萄球菌」(MRSA),就是此種機制。
第三種是改變新陳代謝,即若遇到抗生素阻礙代謝,其代謝作用與路徑會改變或迂迴找尋其他路徑,最終仍完成存活必要的代謝過程。
第四種抗藥性機制,張上淳比喻,就像是形成「防護罩」,改變細胞璧結構、不讓抗生素穿透進去,或是用主動幫浦抽水(pump out)機制,將進入細胞的抗生素排除出去。
「抗生素過度使用」,是細菌產生抗藥性的最主要因素,張上淳說。
突變基因繁殖擴大
細菌在複製、繁殖過程中,可能會產生突變,子代複製錯誤導致 DNA 序列改變,變得跟親代不同。多數帶有突變基因的個體可能因不適應環境而無法存活,但也可能以相當低的機率存活下來(在複製過程突變發生率約為10的10到15次方分之一的機率),因此細菌也可能因合成酵素能力發生突變,因而產生對抗、抵制抗生素的能力。
雖然偶發的突變個體對整體細菌群落而言屬於小眾,但若人類頻繁地使用許多抗生素,反而會讓這些帶有突變基因的細菌獲得生存優勢,進而繁殖、擴大這種帶有突變基因細菌的數量。
另外,不靠自體突變,直接從別的細菌體內獲得抗藥性基因,也是一種產生抗藥性的方法。細菌有能力進行個體間遺傳物質的水平傳遞交換。
廖有地比喻,細菌跟細菌就像兩艘戰艦,其中一艘使用小艇輸送抗藥性基因去另一艘戰艦。發生這種水平傳遞抗藥性基因狀況時,兩菌之間必須要接近,需要有一定的濃度,或是親緣關係相近等各樣條件,才可能成功傳遞抗藥性基因。
超級細菌解析/抗生素 造成抗藥性更強細菌
2010/11/01
【聯合報╱記者劉惠敏】
目前已知帶有抗藥性基因 NDM-1的細菌,主要屬於腸道菌科,最常見於大腸桿菌、克雷白氏肺炎桿菌等。此抗藥性基因最早發現於2008年,在印度醫院住院病人身上的克雷白氏肺炎桿菌中測得,隔年英國偵測到腸道菌中帶有 NDM-1抗藥性基因比例增加,其後美國、加拿大、荷蘭等國也陸續傳出零星案例報告,不過仍有兩種抗生素對此類帶有抗藥性基因的細菌有效。
同類的多重抗藥性基因還有 VIM基因、KPC基因等。以帶有KPC基因的克雷白氏菌為例,國內迄今尚未出現,不過在美國紐約等地相當普遍;近日帶有KPC基因的「碳青黴烯酶(carbapenemase)肺炎克雷白菌」在巴西現蹤,巴西官方公布在境內十六家醫療院所發現該菌,且於巴西首都已奪走至少15條人命。
衛生署副署長、臺大醫學系教授張上淳提醒,醫療院所雖是超級細菌成長散布的危險地帶,卻也是人類對抗超級細菌的重要戰場。
因為具抗藥性基因細菌多是透過傷口(包括手術傷口)傳播感染,醫院又是大量使用抗生素之地,特別是加護病房,病人多抵抗力低、有開放性傷口,或是插管、插導尿管,極易遭受超級細菌侵襲。
然而,雖然成為帶菌者卻未必會立刻感染疾病或具傳染性,在一般環境因為有許多天然細菌群落,超級細菌不一定能存活並擴散。也因此,面對受NDM-1感染的健康帶菌者,臨床上醫生通常不建議使用僅剩的那兩種抗生素治療,其理由一是腸道內殺菌效能有限,二是不希望過度使用抗生素,造成更強抗藥性細菌出現。
他強調,要減少抗藥性細菌產生,除了更謹慎、節制使用預防性抗生素,病人也應遵照醫囑使用抗生素。醫護、民眾都應記得多消毒洗手、做好基本個人衛生,也有助減少細菌擴散。
中央研究院生醫所副所長廖有地提醒,畜牧養殖業過度使用抗生素,造成環境可能篩選出更多抗藥性細菌的現象,也不可忽視。
張上淳也說,在大型畜牧養殖場,通常會使用預防性抗生素減少傳染病,甚至在飼料中加入抗生素,讓動物生長更迅速健康,但這也讓細菌更容易產生抗藥性。
雖然如此,也不必太過悲觀。例如數年前歐洲發現另一種超級細菌「萬古黴素抗藥性腸球菌」,就是因為畜牧業大量使用萬古黴素導致,後來歐盟禁用萬古黴素後,這種抗藥性超級細菌就逐漸減少了。
抗生素百百種 部分人工合成
欲了解超級細菌,得先從抗生素的歷史談起。
1928年蘇格蘭生物化學家佛萊明 (Alexander Fleming)在實驗室培養金黃色葡萄球菌,意外發現金黃色葡萄球菌生長的培養皿中,長了一塊青黴菌菌落其周圍沒有細菌滋長,這是科學界第一次發現能抑制、消滅細菌的「敵手」。1935年英國病理學家弗洛里(Howard Walter Florey)、德國生物化學家錢恩(Ernst Boris Chain),藉由純化技術,從青黴中萃取出青黴素(penicillin)。1941年人類首次使用抗生素盤尼西林,對抗細菌造成的感染疾病,讓人類與畜養動物在對抗傳染病的生死搏鬥中,取得了優勢。
衛生署副署長、感染科專家張上淳表示,就像「盤尼西林」,多數抗生素最初都是自然環境中原本就存在的物質。其後人工研發出的半合成抗生素,是透過人工修飾、改變抗生素組成,即其化學中心結構不變,但增加或改變化學結構式的「側鍊」,就可製造出一系列的抗生素。
例如有些可與細菌競爭、抑制其他生物生長的黴菌,科學家在分析其結構後,純化出其中具抗菌能力的特定化學物質如「盤尼西林」等,若增加碳或氫分子於其側鍊,就可產生不同抗生素如 Ampicillin (安比西林)、Mezlocillin(美洛西林)。
而抗生素側鍊只要些微改變,就能讓原有抗生素抑制、殺菌的能力明顯不同,例如盤尼西林可對抗鏈球菌、葡萄球菌等,但安比西林就多了對抗大腸桿菌的能力。
張上淳表示,如今醫學上可使用的抗生素相當多,由於其分類繁複,到底有多少種抗生素,並沒有標準答案。除了半合成的抗生素,目前也有少數抗生素,是完全由人工合成,光是成分就有上百種之多,臨床醫療上常使用的抗生素至少有 70到80種。
你可能會有興趣的文章:
限會員,要發表迴響,請先登入